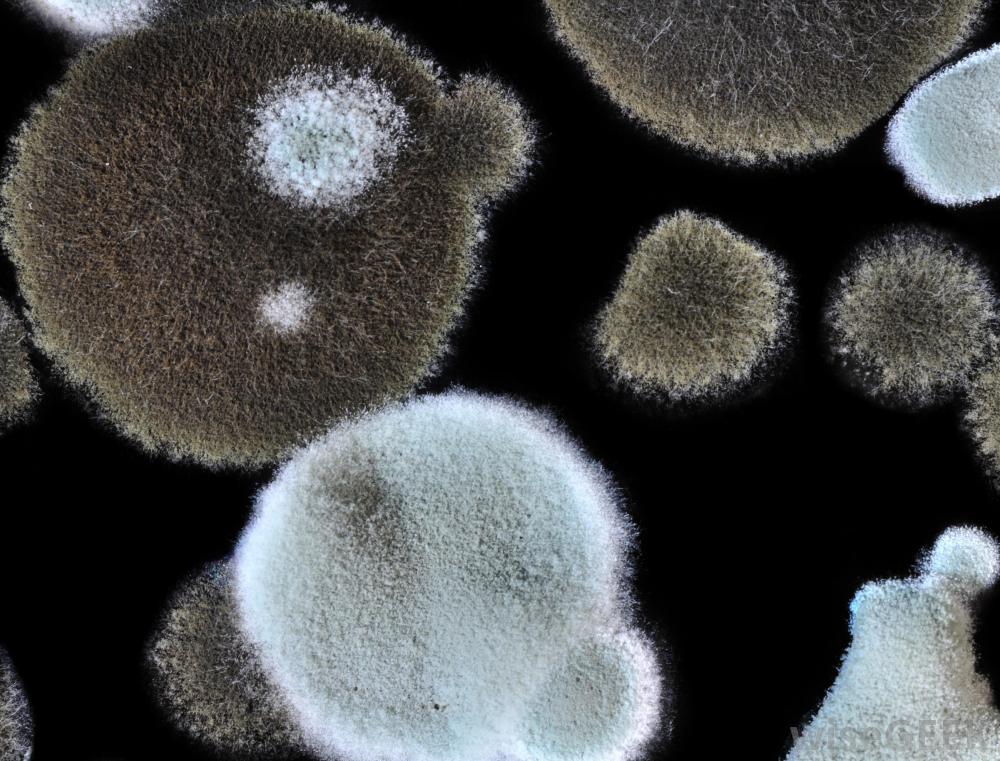

防霉剂含有防止霉菌在各种建筑表面和食品上生长的化学物质。用于去除霉菌生长的霉菌清洁剂含有防止霉菌返回清洁表面的抑制剂。预防性抑制剂覆盖吸水性建筑材料和牲畜饲料以杀死霉菌孢子两种类型都使用相似的化学物质...
防霉剂含有防止霉菌在各种建筑表面和食品上生长的化学物质。用于去除霉菌生长的霉菌清洁剂含有防止霉菌返回清洁表面的抑制剂。预防性抑制剂覆盖吸水性建筑材料和牲畜饲料以杀死霉菌孢子两种类型都使用相似的化学物质和方法来延缓霉菌的生长,保护生活在潮湿地区的人们,防止牲畜饲料在室外筒仓中变质。

霉菌可以在任何多孔材料上滋生,包括木材和纺织品建筑结构中的防霉措施确保了居住或工作人员的安全。有毒的霉菌会释放孢子到空气中,导致呼吸系统问题,甚至对霉菌过敏的人产生更严重的问题。吸收性建筑材料会吸收水分。用防霉剂处理这些类型的建筑材料可以阻止霉菌孢子附着和生长。这是在建筑施工阶段应用于材料上的,在建筑的设计寿命期间,只需要一层就可以为材料提供保护

接触霉菌会导致鼻窦问题从建筑表面去除已形成的霉菌菌落需要不同类型的防霉剂。用于去除霉菌的清洁剂含有杀死活的霉菌菌落并防止霉菌在清洁后返回到材料中的化学物质。这种防霉剂中使用的化学物质要求使用清洁剂的人员佩戴口罩,以避免被清洁剂释放的烟雾和霉菌在清洁剂中死亡时释放的孢子淹没。另一种防霉剂不含有毒化学物质,是一种稳定的提高放牧牲畜饲料产量的药物

霉菌通常会在干草中生长。喂给家畜的玉米、小麦和干草为霉菌的生长提供了理想的环境。在牲畜饲料中生长的霉菌菌落导致了饲料破坏,增加牧场主和农民的成本,并可能毒害牲畜。这种类型的防霉剂直接添加到饲料中,两种成分完全混合,以确保饲料的所有表面都涂有抑制剂。当抑制剂涂层饲料喂给牲畜时,抑制剂被摄入并且不会对牲畜饲料的喂养造成不良影响。在某些容易因霉菌生长而变质的农产品中添加同一类型的防霉剂。

可安装排水熨平板作为预防措施防霉
防霉剂可能有助于防止霉菌在食品上生长。

市面上有各种旨在抑制浴室霉菌生长的产品

霉菌的存在会导致呼吸系统问题。

面罩应该在怀疑有霉菌的地方一定要佩戴。